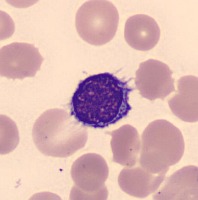
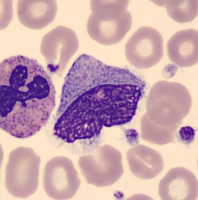
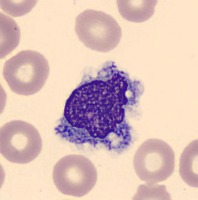

Clean_CBC Computer Vision Project
Cite This Project
If you use this dataset in a research paper, please cite it using the following BibTeX:
@misc{
clean_cbc_dataset,
title = { Clean_CBC Dataset },
type = { Open Source Dataset },
author = { Why },
howpublished = { \url{ https://universe.roboflow.com/why/clean_cbc } },
url = { https://universe.roboflow.com/why/clean_cbc },
journal = { Roboflow Universe },
publisher = { Roboflow },
year = { 2023 },
month = { dec },
note = { visited on 2024-05-13 },
}
Connect Your Model With Program Logic
Find utilities and guides to help you start using the Clean_CBC project in your project.
Similar Projects
leukemia-cells
694 images
WBC
694 images
bloodcells
592 images
RBC-wBC-Platelet
5751 images
blood-cells
673 images